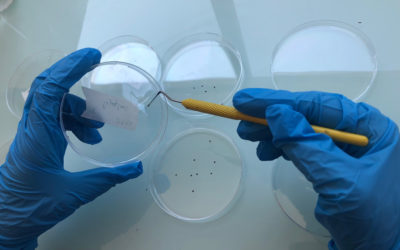

Actualités du centre de recherche et de formations
Avril 2020, Apinov innove !
Nous profitons du calme du Centre de formations pour vous dévoiler notre nouvelle identité visuelle. Après 13 ans d’existence, le logo Apinov s’offre une remise en beauté alliant modernisme, dynamisme et expertise. Cette nouvelle signature identitaire résume l’expertise du « Centre de recherche & formations apicoles », tout en soulignant nos valeurs fondatrices de la convivialité et du partage des connaissances.
Un début d’année qui rime avec nouveautés…
Et oui ce début d'année 2020 rime avec nouveautés pour l'équipe des formateurs Apinov.Ce sont déjà 6 sessions de formations qui se sont déroulées au...
Un nouveau partenariat : “It’s my BEEsiness”
Avec un peu de retard, nous tenions à vous annoncer notre partenariat avec « It’s my Beesiness ». Ce projet, lancé par trois étudiants ingénieurs agronomes à Bordeaux, a vu le jour durant les années scolaires 2018-2019 et 2019-2020.
Conférence SIMAPI : Etude des sensibilités de Varroa destructor aux acaricides
Gabrielle Almecija, Doctorante et chargée d’études techniques et scientifiques chez Apinov présente le bilan de l’année 2019 sur l’état de sensibilité des Varroas en France lors d’une conférence ce 6 décembre au SIMAPI d’Avignon.